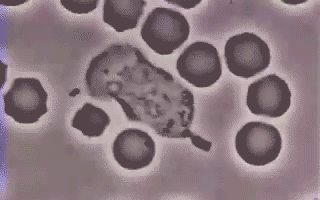

来意:生命时报
很多阳性患者会发现,自己感染奥密克戎后,症状总是时好时坏。
往往在白天没有明显症状,但是一到晚上就发热咳嗽、浑身酸痛。有网友表示,一到晚上准备好好休息,反而症状都跑出来了。

为什么感染症状总会在夜间加重?《生命时报》(微信内搜索“LT0385”即可关注)结合研究并综合专家观点,教你应对各种不适。
免疫系统在晚上更活跃
当免疫系统与病毒“搏斗”时,人体内的一系列症状就会更加明显。
到了晚上,免疫系统会比白天更活跃。所以,患者会感觉晚上更容易发烧、咳嗽、浑身疼痛。
影响免疫系统活跃度的是一种叫做皮质醇的物质。它又叫“压力荷尔蒙”,是人体应对外界压力时所分泌出的一种激素。
皮质醇的分泌会影响免疫系统的工作。白天,皮质醇分泌增多,免疫系统的活跃程度降低;夜间,皮质醇分泌减少,免疫系统的“战斗”就会变得更加激烈。

因此,感染后晚上症状表现得比较明显,其实也说明了免疫系统正在努力清除病毒。
4种不适该如何缓解
感染后,一些人会出现发热、乏力、咽痛、咳嗽等不适,到了夜间甚至影响睡眠。此时可以根据症状服用药物,或通过物理方法缓解。
发烧、头痛
发烧时要保证充分休息。多喝水可以补充体内丢失的水分,且有利于通过代谢帮助人体散热。

用32℃~34℃的温水擦拭皮肤,可促进散热。按双上肢、背部、双下肢的顺序进行,腋窝、肘窝、手心、腹股沟、腘窝等部位可稍用力,擦浴时间不要超过20分钟。
39℃以上的高热患者可以用毛巾包裹冰袋,置于腋窝、腹股沟及腘窝等血管丰富处,帮助身体降温。
咽痛
咽痛严重时,可以试试盐水漱口。将7.5克食盐溶解在250毫升温水中,每隔3小时漱口一次。注意不要使用刺激性强的漱口水,以免加剧呼吸道干燥。
咳嗽
平躺时,呼吸道中的分泌物容易积聚,会加重咳嗽,尤其在晚上。
最好将头颈和背部从高到低同时垫高,比如,用两个枕头,一个横放,另一个竖着搭在上面,呈“T”字形。
鼻塞、流鼻涕
鼻塞时,可以使用赛洛唑啉滴鼻剂;流鼻涕时,可选择抑制过敏反应的抗组胺药物,兼有缓解鼻塞作用,如氯苯那敏、氯雷他定。
还可以试试盐水冲洗鼻子,可以把鼻涕、病毒细菌等刺激物冲走,降低局部炎性介质的浓度,有助保持呼吸通畅。

可以打开加湿器,或将热水倒入杯中,缓缓深吸蒸气5~10分钟,早晚各一次。多喝水有助稀释黏液,也能帮助缓解鼻塞。
有些症状加重需警惕
北京协和医院呼吸与危重症医学科最新发布的《新冠肺炎诊疗参考方案(2022年12月版)》中提到,出现以下情况需要考虑病情加重可能:
低氧血症加重或吸氧需求增加;呼吸困难症状加重;炎症指标或乳酸显著升高;心肌酶、肝酶和肌酐水平升高;淋巴细胞计数进行性下降;肺部影像学迅速进展。

另外,如果出现以下几种情况,建议及时就医。
血氧饱和度下降
有基础疾病的患者和老年人,家中应常备一个血氧仪,及时监测血氧饱和度。如果血氧饱和度小于90%,需尽快到医院就诊。
如果没有血氧仪,也可以通过监测呼吸频率变化,辅助识别是否可能有重症危险。
在安静状态下,健康成人呼吸频率为每分钟12~20次;儿童较成年人呼吸频率更快,1~3岁儿童为每分钟25~30次,4~7岁儿童为每分钟20~25次。
如果呼吸频率明显加快,增加幅度超每分钟10次,就提示要特别关注。
具体方法:静息状态下,数一下患者一分钟内的呼吸次数,如果超过30次要警惕。如果呼吸频次看不清楚,也可以根据胸廓起伏的频次来数。
胸闷、心悸
北京大学人民医院心内科主任医师刘健介绍,发生病毒性心肌炎,患者早期可能出现疲乏无力、胸闷气短、心悸头晕、食欲不振、恶心呕吐、呼吸困难、胸痛等症状。如果感染者出现以上症状,一定要提高警惕。
若症状进一步加重,或出现心律失常、心动过速或缓慢等症状,要尽快到医院检查,通过心电图可发现心肌损伤改变。

这时若能早期诊断和治疗,大多预后良好。如果病情继续发展,往往会急转直下,可能引起心力衰竭,出现休克,甚至猝死。
咳嗽不愈、呼吸困难
武汉市肺科医院呼吸与危重症医学科副主任医师杨澄清提醒,如果有上、下呼吸道症状,且高烧39°C以上持续3天还没退烧,或中低热持续超过1周,需要防范肺炎。
临床上,咳嗽咳痰是肺炎最常见的症状之一。如果发热时伴有咳嗽、大量黄色脓痰症状,影响到生活、睡眠等,也要引起重视。
严重焦虑、失眠
疫情期间,有些人容易出现焦虑、失眠等情况。如果相关负面情绪持续超2周,一定要积极进行心理调适。
中国疾病预防控制中心营养与健康所研究员付萍建议,可以进行适度的有氧运动、正念打坐、冥想等自我调适,也可与家人、朋友多交流,必要时应寻求专业心理医生的帮助。▲


